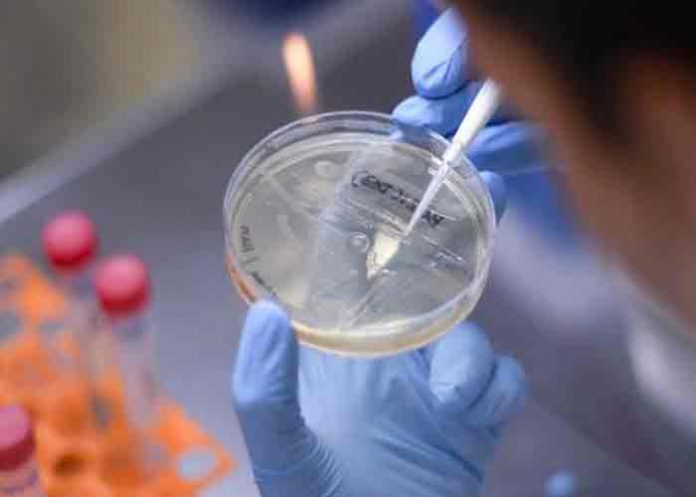
variante- vietnam, nueva variante, covid-19-

Vietnam ha descubierto una nueva variante del virus de la COVID-19, que sería una combinación de las variantes india y británica; informaron el sábado los medios de prensa oficiales.
La noticia sale a la luz en un momento en que el país se enfrenta a una nueva ola de contagios en más de la mitad de su territorio; incluyendo las zonas industriales y las grandes ciudades como Hanói y Ho Chi Minh.
Hasta ahora, Vietnam se había visto relativamente protegido del virus y la mayoría del total de 6 700 casos y 47 fallecidos registrados se produjeron desde abril.
Te puede interesar: Chile anuncia su primer caso de ‘hongo negro’ vinculado a la COVID-19
Características de la nueva variante
«Hemos descubierto una variante híbrida, que combina la india y la británica», dijo el sábado el ministro de Salud, Nguyen Thanh Long, en una reunión sobre la pandemia.
«La característica principal de este virus es que se transmite rápidamente por el aire. La concentración de virus en la garganta y en la saliva aumenta rápidamente y se extiende velozmente en un entorno cercano», agregó.
El responsable no detalló cuántos casos de esta nueva variante se han registrado hasta el momento y aseguró que sus características serán publicadas pronto para que quede registrada.
Según medios locales, la secuenciación genética realizada por el Instituto Nacional de Higiene y Epidemiología ha revelado que al menos cuatro pacientes con covid-19 en el país asiático portan la variante híbrida.
También puedes ver: Venezuela inicia nueva fase de vacunación contra la covid-19
Hasta este momento, Vietnam había registrado siete variantes del virus. El país había sido elogiado por su gestión de la primera ola de la pandemia el año pasado; frente a la que aplicó cuarentenas masivas y un estricto sistema de diagnóstico y aislamiento.
En este momento, y ante el aumento de los contagios; los movimientos están muy limitados en el país y los lugares de ocio y de culto están cerrados en varias regiones.
Por rpp.pe